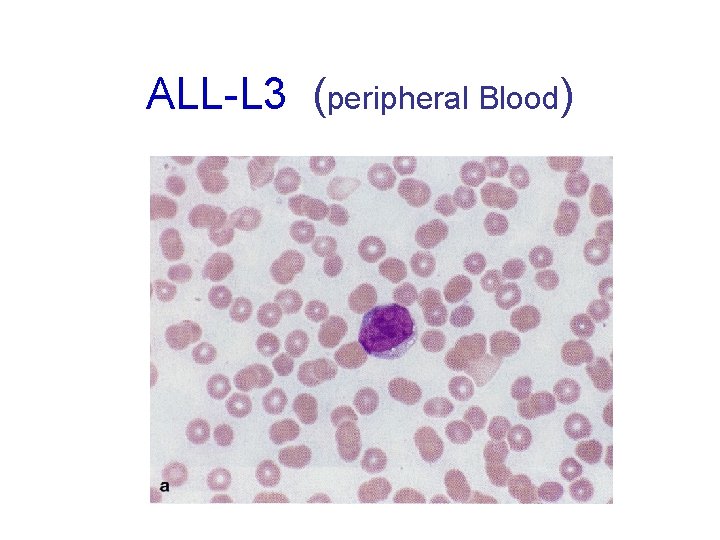
ALL-L 3 (peripheral Blood)
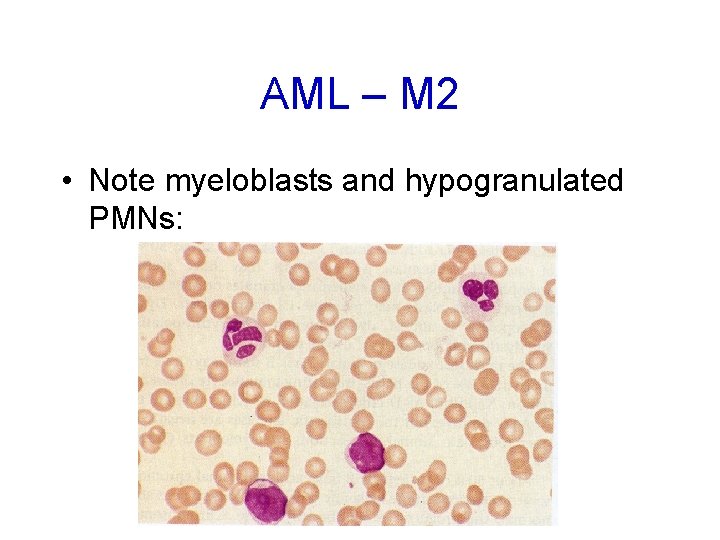
AML – M 2 • Note myeloblasts and hypogranulated PMNs:
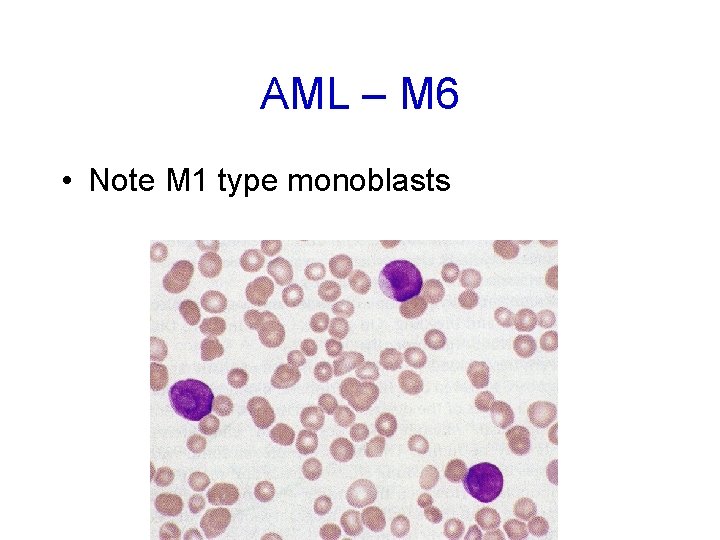
AML – M 6 • Note M 1 type monoblasts

The Acute Leukaemias Ahmad Sh Silmi Msc Haematology

- Slides: 70
The Acute Leukaemias Ahmad Sh. Silmi Msc Haematology, FIBMS
What Is Acute Leukemia? • The acute leukaemias are a heterogeneous group of malignant disorders, which are characterized by the uncontrolled clonal proliferation and accumulation of poorly differentiated blast cells in the bone marrow and other tissues. • Thus replacement of normal bone marrow elements with abnormal (neoplastic) blood cells. • These leukaemic cells are frequently (but not always) present in the peripheral blood stream. Subsequently there is a raised total blood count and evidence of bone marrow failure (i. e. anaemia, neutoropenia, thrombocytopenia) are ensues. • In the acute leukaemias the blasts commonly invade reticuloendothelial tissues including the spleen, liver and lymph nodes. They may also invade other tissues, infiltrating any organ of the body. • If left untreated, leukaemia eventually causes death.
ALL naïv e B-lymphocytes Lymphoid progenitor Plasma cells T-lymphocytes AML Hematopoietic stem cell Myeloid progenitor Neutrophils Eosinophils Basophils Monocytes Platelets Red cells
Myeloid maturation myeloblast promyelocyte metamyelocyte band neutrophil MATURATION Adapted and modified from U Va website
Acute Leukemia • accumulation of blasts in the marrow
Marrow failure • neutropenia: • anemia: • thrombocytopenia: infections, sepsis fatigue, pallor bleeding
Demographics of Leukemia Patients (2001 Data( CLL=Chronic Lymphocytic ALL=Acute Lymphocytic CML=Chronic Mylogenous AML=Acute Mylogenous Sources from Leukemia, Lyphoma, Myeloma Facts 2001 Total Reported Cases = 31, 500
Acute Leukaemogenesis • The acute leukaemias are thought to develop as a result of a genetic alteration within a single stem cell in the bone marrow. Which means, a blockage of maturation at certain level; this reveals an abnormal regulatory mechanism, and the cell is incapable for further proliferation and differentiation, but it still has the ability to divide. • Successive mitotic division in the progeny of the cell produces a clonal population, which once it is sufficient a clonal mass has been achieved, and gives rise to the clinical manifestation of the disease.
Two-hit model of leukemogenesis Loss of function of transcription factors needed for differentiation eg. AML 1 -ETO CBFb-SMMHC PML-RARa differentiation block + Gain of function mutations of tyrosine kinases eg. FLT 3, c-KIT mutations N- and K-RAS mutations BCR-ABL TEL-PDGFb. R enhanced proliferation Acute Leukemia
Development of Leukemia in the Bloodstream Stage 1 - Normal Stage 2 - Symptoms Stage 3 - Diagnosis Legend White Cell Stage 5 a- Anemia Red Cell Platelet Blast Stage 4 - Worsening Germ Stage 5 b- Infection Sources from Leukemia, by D. Newton and D. Siegel
Lab evaluation – The lab diagnosis is based on two things – Finding a significant increase in the number of immature cells in the bone marrow including blasts, promyelocytes, promonocytes (>30% blasts is diagnostic) – Identification of the cell lineage of the leukemic cells – Peripheral blood: • Anemia (normochromic, normocytic) • Decreased platlets • Variable WBC count – The degree of peripheral blood involvement determines classification: » Leukemic – increased WBCs due to blasts » Subleukemic – blasts without increased WBCs » Aleukemic – decreased WBCs with no blasts
Classification of the immature cells involved may be done by: 1 - Morphology – an experienced morphologist can look at the size of the blast, the amount of cytoplasm, the nuclear chromatin pattern, the presence of nucleoli and the presence of auer rods (are a pink staining, splinter shaped inclusion due to a rod shaped alignment of primary granules found only in myeloproliferative processes) to identify the blast type: • AML – the myeloblast is a large blast with a moderate amount of cytoplasm, fine lacey chromatin, and prominent nucleoli. 10 -40% of myeloblasts contain auer rods.
Myeloblasts with auer rods
Morphology, cont. • ALL – in contrast to the myeloblast, the lymphoblast is a small blast with scant cytoplasm, dense chromatin, indistinct nucleoli, and no auer rods Lymphoblast
FAB • In an attempt to improve the reproducibility and comparability of the classification process, a grouped of expert haematologists from French, America, and Britian (FAB) collaborated to define a more objective criteria for the classification of acute leukaemias. • The initial FAB study was based on the examination of more than 200 different cases of acute leukaemia by expert morphologists, in addition, a myeloperoxidase or suddan black stains should be used to facilitate the recognition of myeloblasts.
Classification of leukemia Main classification Acute leukemia Chronic leukemia FAB Lymphoid Myeloid Lymphoid Myeloid L 1 L 2 L 3 AML M 0 M 1 M 2 M 3 M 4 M 5 M 6 M 7
FAB Characterization for ALL • L 1: Homogenous population of small lymphoblasts with scanty cytoplasm and scanty nucleoli. Nucleus occasionally cleft. • L 2: Heterogeneous population of large lymphoblasts with moderately abundant cytoplasm & or more nucleoli. Nucleus commonly intended or cleft. • L 3 -Burkitt’s type: Homogenous population of large lymphoblasts with prominent nucleoli & deeply basophilic, vacuolated cytoplasm.
Acute Non-Lymphoblastic Leukaemia Diagnosis Alternative M 0 Bone Marrow Appearance Identified by ultrastructural myeloperoxidase activity or immunophenotyping. M 1 AML without maturation M 2 AML with maturation M 3 APL M 4 AMMo. L M 5 AMo. L M 6 AEL M 7 AMeg. L Monomorphic with one or more distinct nucleoli, occasional auer rod and at least 3% myeloperoxidase positivity. 50% OR > myeloblasts & promyelocytes and common single auer rod. Dysplastic myeloid differentiation may also be present. Dominant cell type is promyelocyte with heavy azurophilic granulation. Bundles of Auer rods confirm diagnosis. Microgranular variant exist (M 3 v) As M 2 but > 20% promonocytes & monocytes. > 80% monoblasts is poorly differentiated (M 5 a) > 80% monoblasts, promonocytes or monocytes is well differentiated (m 5 b) >50% bizzar, dysplastic nucleated red cells with multinucleate forms and cytoplasmic bridging. Myeloblasts usually > 30%. Fibrosis, heterogeneous blasts population with cytoplasmic blebs. Platelet peroxidase positive.
Acute leukemias • Acute lymphoblastic leukemia – – They may be classified on the basis of the cytological features of the lymphoblasts into; • L 1 - This is the most common form found in children and it has the best prognosis. The cell size is small with fine or clumped homogenous nuclear chromatin and absent or indistinct nucleoli. The nuclear shape is regular, occasionally clefting or indented. The cytoplasm is scant, with slight to moderate basophilia and variable vacuoles. • L 2 – This is the most frequent ALL found in adults. The cell size is large and heterogenous with variable nuclear chromatin and prominent nucleoli. The nucleus is irregular, clefting and indented. The cytoplasm is variable and often moderate to abundant, the basophilia is variable and may be deep, and vacuoles are variable.
ALL-L 1 (peripheral Blood)
ALL-L 1 (Bone Marrow)
ALL-L 2 (peripheral Blood)
ALL-L 2 (Bone Marrow)
Acute leukemias • L 3 – This is the rarest form of ALL. The cell size is large, with fine, homogenous nuclear chromatin containing prominent nucleoli. The nucleus is regular oval to round. The cytoplasm is moderately abundant and is deeply basophilic and vacuolated.
ALL-L 3 (peripheral Blood)
ALL-L 3 (Bone Marrow)
Acute leukemias – Incidence – ALL is primarily a disease of young children (2 -5 years), but it can also occur in adults – Clinical findings – pancytopenia with resulting fatigue, pallor, fever, weight loss, irritability, anorexia, infection, bleeding, and bone pain. – L 1 occurs in children, L 2 in adults, and L 3 is called Burkitts leukemia
Acute leukemias – Prognosis – age, WBC count, and cell type are the most important prognostic indicators • Patients younger then 1 and greater than 13 have a poor prognosis • If the WBC count is < 10 x 109/L at presentation, the prognosis is good; If the WBC count is > 20 x 109/L at presentation the prognosis is poor • T cell ALL (more common in males) has a poorer prognosis than any of the B cell ALLs which have a cure rate of 70%
Acute leukemias • Acute myeloid leukemia (also called acute granulocytic leukemia) – classification depends upon – – – Bone marrow blast morphology Degree of cell maturation Cytochemical stains Immunophenotyping AML is divided into 7 different classifications: • M 1 – myeloblastic without maturation – The bone marrow shows 90% blasts and < 10% promyelocytes – The disease occurs in older adults
AML – M 1 • Note the myeloblasts and the auer rod:
Acute leukemias • M 2 – myeloblastic with maturation – The bone marrow shows 30 -89% blasts and > 10% promyelocytes; – This is characterized by an 8, 21 chromosomal translocation – This occurs in older adults • M 3 – hypergranular promyelocytic – – – This form of AML has a bone marrow with >30% blasts Is more virulent than other forms Occurs with a medium age of 39 The WBC count is decreased Treatment causes a release of the granules and may send the patient into disseminated intravascular coagulation and subsequent bleeding – It is characterized by a 15, 17 chromosomal translocation
AML – M 2 • Note myeloblasts and hypogranulated PMNs:
AML – M 3 • Note hypergranular promyelocytes:
Acute leukemias • M 3 m – hypogranular promyelocytic – – The bone marrow has > 30% blasts – The WBC count is increased. – Like the M 3 type, treatment causes a release of the granules and may send the patient into disseminated intravascular coagulation and subsequent bleeding and – It is characterized by a 15, 17 translocation • M 4 – acute myelomonoblastic leukemia – Both myeloblasts and monoblasts are seen in the bone marrow and peripheral blood – Infiltration of extramedullary sites is more common than with the pure granulocytic variants
AML – M 3 m • Note hypogranular promyelocytes:
AML – M 4 • Note monoblasts and promonocytes:
Acute leukemias • M 5 – acute monoblastic leukemia – >80% of the nonerythroid cells in the bone marrow are monocytic – There is extensive infiltration of the gums, CNS, lymph nodes and extramedullary sites – This form is further divided into » M 5 A - Poorly differentiated (>80% monoblasts) » M 5 B - Well differentiated (<80% monoblasts) • M 6 – erythroleukemia – This is rare and is characterized by a bone marrow having a predominance of erythroblasts – It has 3 sequentially morphologically defined phases; » Preponderance of abnormal erythroblasts » Erythroleukemia – there is an increase in both erythroblasts and myeloblasts » Myeloblastic leukemia – M 1, M 2, or M 4 – Anemia is common
AML – M 5 A • Note monoblasts:
AML-M 5 B • Note monoblasts, promonocytes, and monocytes:
AML – M 6 • Note M 1 type monoblasts
Acute leukemias • M 7 - Acute megkaryoblastic leukemia – This is a rare disorder characterized by extensive proliferation of megakaryoblasts, atypical megakaryocytes and thrombocytopenia
2 - The Cytochemistry ___________ALL______AML_____ • • • Myeloperoxidase - + Suddan black - + Non-specific esterase - + in M 4, M 5 Periodic acid Schiff (PAS) + in c-ALL + in M 6 Acid phosphatase + in T-ALL + in M 6
3 - The Immunological • Immunologic markers (immunophenotyping) – these are used mainly for lymphocytes, i. e. , for determining B cell or T cell lineage. These tests rely on antibodies made against specific surface markers. They constitute what we would call the primary antibody and in an indirect assay they are allowed to react with the cells and unbound antibody is then washed away. Fluorescently labeled antibody (secondary antibody) against the primary antibody is added and allowed to react and then unbound secondary antibody is washed away. The cells are then sent through a flow cytometer that will determine the number of cells that have a fluorescent tag and which are thus positive for the presence of the surface marker to which the primary antibody was made. In a direct assay, the primary antibody is fluorescently labeled.
Direct versus indirect labeling of antigens
Flow cytometer
Terminal deoyxtidyl transferase • This is a unique DNA polymerase present in stem cells and in precursor B and T lymphoid cells. High levels are found in 90% of lymphoblastic leukemias. It can also be detected using appropriate antibodies and flow cytometry.
3 - Classification upon The Immunological Approach • First: The AML FAB classification : It has revealed that the blasts are usually CD 13+, CD 33+ and Td. T-. Special antibodies are helpful in AML M 6 and M 7 which show that M 6 has glycophorin A + and M 7 has CD 41, 42, 61+.
Second: The ALL-FAB classification is: • Precursor B-ALL which is CD 19+, cytoplasmic CD 22+ and Td. T+, includes three subtypes, common-ALL which is CD 10+, null type which is CD 10 - and pre-B-ALL which shows intracytoplasmic m chains ( and may be CD 10+ 0 r CD 10 - ). • B-ALL which shows surface immunoglobulin (Ig) and Td. T. • T-ALL which shows T-cell antigens CD 7+, cytoplasmic CD 3+ and Td. T+. • B-ALL usually corresponds to the morphological L 3 type whereas the CD 10+, null, pre-B or T types may all be L 1 or L 2 and are morphologically indistinguishable.
B cell maturation
T cell maturation
4 - Cytogenetics • Cytogenetics – cytogenetics studies can now be used for diagnosis and for prognosis of hematologic malignancies. – Many leukemias (and lymphomas) are characterized by specific chromosomal abnormalities, including specific translocations and aneuploidy. The specific type of malignancy can be identified based on the specific abnormality or translocation. These may be identified by » Looking at the karyotypes of the chromsomes from the abnormal cells » DNA based tests – these tests are very useful for following the course of the disease – A normal karyotype is usually associated with a better prognosis.
Chromosomal translocation
Chromosome karyotyping
4 - Cytogenetics Type of Leukaemia Chromosomal Abnormality FAB Type ALL t (9; 22 ) L 1, L 2 Pre-B ALL t (1; 19 ) L 1 B ALL t (8; 14 ) t (8; 22) t (2; 8 ) L 3 T ALL t (11; 14) L 1, L 2 AML t (8; 21) M 2 APL t (15; 17) M 3 Amo. L del/t (11) M 5 inv 16, and t (16; 16) M 4 t (8; 16) M 6 AMMo. L AEL
Pathophysiology of the Acute Leukaemias Acute leukaemia causes morbidity and mortality through three general mechanisms: • Deficiency in normal blood cell number or function. • Invasion of vital organs with impairment of organ function. • Systemic disturbances shown by metabolic imbalance.
First: Deficiency in normal blood cell number or function • Infection • Haemorrhage • Anaemia
Constitutional symptoms • fever and sweats common • weight loss less common
2 nd: Infiltration of tissues/organs • enlargement of liver, spleen, lymph nodes • gum hypertrophy • bone pain • other organs: CNS, skin, testis, any organ
Gum hypertrophy
Chloromas A B C NEJM 1998
Leukostasis • Leukostatic tumours accumulation of blasts in microcirculation with impaired perfusion • lungs: hypoxemia, pulmonary infiltrates • CNS: stroke • only seen with WBC >> 50 x 109/L (Hyperleucocytosis )
Sanctuary site relapse • Leukaemic infiltration of the testes and meninges provide an effective sanctuary for resident laeukaemic blasts because cytotoxic drugs poorly penetrate them. • This provides a source for relapse. • Meningeal and testicular relapse are most commonly seen in childhood ALL.
3 rd: Metabolic Disturbances • hyponatraemia is relatively common in ANLL secondary to the production of a vasopressin-like substance by myeloblasts. • Hypokalaemia is also common, especially in AMMo. L and Amo. L secondary to the renal damage. • Spontaneous lysis of blast cells causes the release of abnormally large amounts of purines into the plasma. This results to an increase uric acid or hyperuricaemia. This abnormality may be severe enough to require dialysis, particularly where renal damage is present. • Several of the cytotoxic drugs are nephrotoxic and therefore may increase the severity of minor metabolic disturbances secondary to massive cell lysis.
Laboratory features • WBC usually elevated, but can be normal or low • blasts in peripheral blood • normocytic anemia • thrombocytopenia • neutropenia • DIC
Bone marrow in acute leukemia • • necessary for diagnosis useful for determining type useful for prognosis Acute leukemias are defined by the presence of > 20% blasts in bone marrow (% of nucleated marrow cells(
Distinguishing AML from ALL • light microscopy – AML: Auer rods, cytoplasmic granules – ALL: no Auer rods or granules. • flow cytometry • special stains (cytochemistry)
AML
AML
Auer rods in AML
ALL